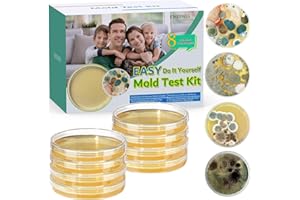
ENESNES Mold Test Kit for Home, 8 Detection Tests for HVAC, Surfaces & Indoor Air Quality, DIY Black Mold Detector Testing kit at Home, Includes Detailed Identification Guide, Free Lab Analysis

MOLD best sellers
Get a list of 1156 MOLD best sellers on Amazon, Shopify, Walmart, Ebay and Wayfair . Period is past 7 days, last updated 2025-01-06.

|
#1 Mold Stain Remover Gel $19.95 on Amazon |
|

|
#2 Mold Control 32 oz Spray $13.48 on Amazon |
|

|
#3 Mold Test Kit for Home $28.99 on Amazon |
|

|
#4 Molded Walker Tray with $23.46 on Amazon |
|

|
#5 Mold & Mildew Remover $4.48 on Amazon |
|

|
#6 Mold Test Kit for Home 7 $14.99 on Amazon |
|

|
#7 Mold Test Kit for Home $14.99 on Amazon |
|

|
#8 Mold Test Kit for Home $13.89 on Amazon |
|

|
#9 🆕 Mold Stain and Mildew $14.34 on Amazon |
|

|
#10 Mold Test Kit for Home $13.89 on Amazon |
|

|
#11 Mold Test Kit for Home $9.99 on Amazon |
|

|
#12 Mold & Mildew Remover $16.99 on Amazon |
|

|
#13 Mold Blocker 32 OZ $9.99 on Amazon |
|

|
#14 🔥 Mold Stain and Mildew $32.26 on Amazon |
|
|
#15 Mold Test Kit for Home $15.99 on Amazon |
|

|
#16 Mold Stain Remover Gel $12.99 on Amazon |
|

|
#17 Molding Auto Waterer $6.03 on Walmart |
|

|
#18 🔥 Mold Test Kit for Home $19.99 on Amazon |
|

|
#19 Mold Stain & Mildew Stain $17 on Amazon |
|

|
#20 Mold and Mildew Remover $13.80 on Amazon |
Similar searches
Suggested best sellers
What's in Bestsellers.ai PRO ?
- 📊 Product Sales Estimates
- 💰 Total Sales Estimates
- 📜 Product Sales history
- 📅 52-Week Sales estimates
- 🔍 Advanced filtering
- ♻️ Second Hand and Refurbished market Data
Who uses Bestsellers.ai PRO ?
Trusted by e-merchants everywhere, Bestsellers.ai is their go-to for deciding what to sell next. Leading brands and retailers rely on us for crucial competitor insights and data-driven choices. 🚀
